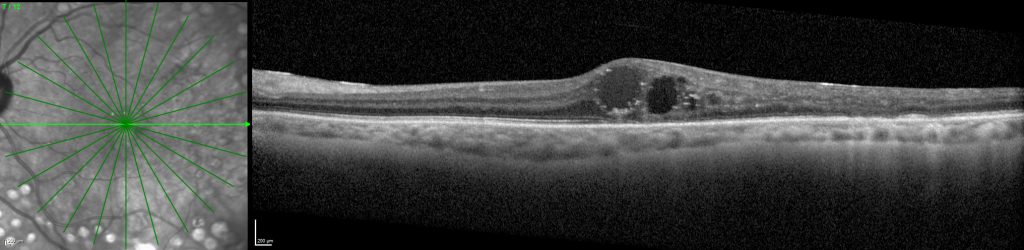

¿Le han diagnosticado Edema Macular Diabético (EMD)? ENSAYO TERMINADO
El Hospital Arruzafa abre un proceso de selección para que los pacientes interesados puedan beneficiarse de manera gratuita de la participación en un ensayo clínico para evaluar la eficacia de un nuevo medicamento para el tratamiento del Edema Macular Diabético.

ENSAYO CLÍNICO CT-P42 3.1
Es un ensayo fase III que compara la eficacia y seguridad de un medicamento en comparación con Eylea en pacientes con Edema Macular Diabético.
¿A QUIÉN ESTÁ DIRIGIDO?
A personas que presenten Edema Macular Diabético y que aún no han recibido tratamiento previo específico para dicha patología. Una vez evaluado el caso, desde la Unidad de Retina y Vítreo del Hospital La Arruzafa explicará al paciente el estudio y se evaluará si cumple con todos los requisitos para poder entrar en el ensayo.
¿EN QUÉ CONSISTE EL ENSAYO CLÍNICO?
Se trata de un ensayo clínico desarrollado en varios centros a nivel internacional que evalúa la eficacia y seguridad del fármaco en investigación, en comparación con otro tratamiento ya existente. Su duración es de 1 año.
OBJETIVO
Evaluar la eficacia y seguridad de un medicamento en investigación en comparación con uno de los tratamientos actuales.
Para más información acerca de este estudio, visite:
https://clinicaltrials.gov/ct2/show/NCT04739306?term=ct-p42+3.1&draw=2&rank=1
